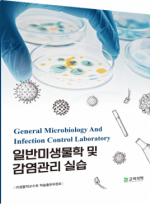
일반미생물학 및 감염관리 실습

Laboratory Medicine 상품리스트
-
의학
내과임상각과
- Anesthesiology
- Dermatology
- Emergency Medicine
- Family Medicine
- Laboratory Medicine
- Neurology
- Nuclear Medicine
- Obstetrics & Gynecology
- Ophthalmology
- Occupation Medicine
- Pain Medicine
- Pediatric
- Physical Therapy
- Preventive Medicine
- Psychiatry
- Surgical Pathology
- Otorhinolaryngology
- Radiology
- Rehabilitation
- Urology
- 간호학
- 한의학
- 약학
- 치의학
 즐겨찾기
즐겨찾기 고객센터
고객센터